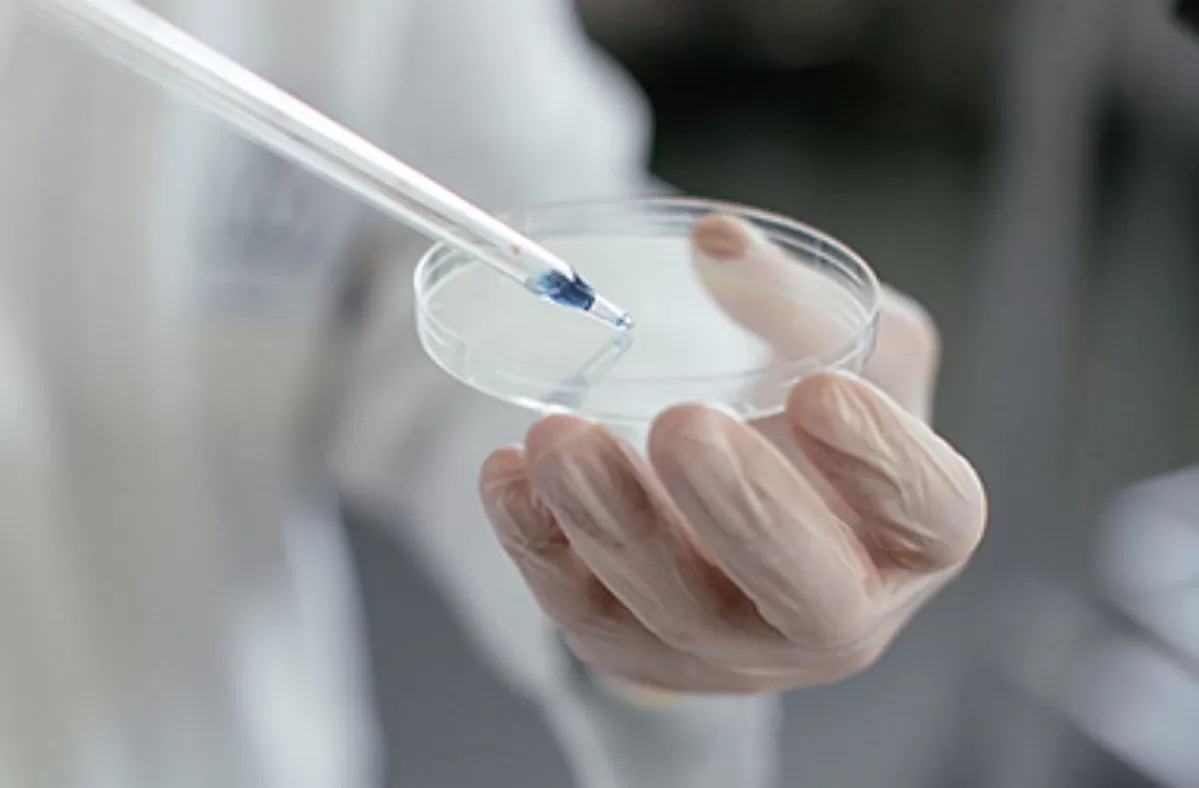
인사이트

차세대 성장동력으로 RPT를 내세운 SK바이오팜의 도전이 국내 바이오 산업의 방향 전환 가능성을 가늠하는 시험대로 떠오르고 있다.
지난 29일 SK바이오팜 황선관 부사장은 서울 코엑스에서 열린 '바이오코리아 2026' 컨퍼런스 세션 '한국형 블록버스터 창출 전략'에서 '제2의 세노바메이트를 향해: SK바이오팜의 경험과 시사점'을 주제로 발표를 이어갔다.
이날 황 부사장은 "2029년 엑스코프리(세노바메이트의 미국 제품명) 연매출 10억 달러(한화 약 1조 4779억 원) 달성에 전력을 다하겠다"며 뇌전증 치료제 '세노바메이트'의 견조한 성적을 토대로 CNS(중추신경계) 파이프라인 확대 및 TPD(표적단백질분해)와 RPT(방사성의약품) 등 신규 모달리티 개발에 집중하겠다는 포부를 드러냈다.
 기사와 관련 없는 자료 사진, SK바이오팜 '세노바메이트' / gettyimgesBank, 사진 제공 = SK바이오팜
기사와 관련 없는 자료 사진, SK바이오팜 '세노바메이트' / gettyimgesBank, 사진 제공 = SK바이오팜
SK바이오팜은 세노바메이트로 단순히 돈을 번 회사가 아니다. 국내 바이오 다수가 후보물질을 기술수출하는 데 그쳤던 것과 달리, SK바이오팜은 '신약을 개발해 직접 팔고, 막대한 수익을 거둔' 드문 경험을 갖고있다.
회사는 기술이전 대신, 후보물질을 발굴, 임상 개발, 허가, 상업화까지 아우르는 '엔드 투 엔드(End-to-End)'전략을 선택했다. 국내 바이오 기업 가운데 이 전 과정을 완주한 곳은 손에 꼽히는데 이 점에서 SK바이오팜은 이미 출발선이 다르다.
세노바메이트가 의미 있는 이유도 단순 매출 규모보다, 그 성공 경험이 다음 투자에 재투입될 수 있는 구조를 만들었다는 데 있다.
현재 SK바이오팜은 최태원 SK그룹 회장의 장녀 최윤정 전략본부장의 주도 아래 RPT를 차세대 성장동력으로 내세웠다.
 SK바이오팜 최윤정 전략본부장 / 사진 제공 = SK바이오팜
SK바이오팜 최윤정 전략본부장 / 사진 제공 = SK바이오팜
RPT 산업은 일반 신약보다 훨씬 복잡한 구조를 갖는다. 후보물질만 좋다고 끝나는 게 아니라 방사성 동위원소를 안정적으로 확보하고 짧은 반감기 안에 생산·운송·투여까지 이어지는 별도의 체계를 필요로하기 때문이다. 즉, 신약 개발을 넘어 치료제 하나를 중심으로 공급망과 인프라까지 함께 확보해야 비로소 완성되는 사업인 것이다.
막대한 비용과 시간 투자를 필수로 요구하다보니 RPT 분야는 글로벌 시장에서도 소수의 기업만이 주도권을 쥐고 있는데, 이 중 하나가 SK바이오팜이다. 국내에서 해당 분야에 도전장을 내밀 수 있는 기업은 더더욱 제한적이다보니 RPT를 차세대 성장축으로 내세운 SK바이오팜의 결정에 업계의 이목이 더욱 집중되고 있다.
특히 SK바이오팜은 RPT를 단순한 파이프라인이 아닌 '별도의 사업 축'으로 분리해 접근하고 있다. 특정 후보물질 개발에 그치는 것이 아니라, 장기적으로 산업 자체를 키우겠다는 전략이다.
실제로 지난 1월, SK바이오팜은 RPT 치료제 후보물질 'SKL35501'에 대해 미국 FDA와 식품의약품안전처로부터 임상 1상 IND 승인을 받았다. 아직 초기 단계지만, 글로벌 임상 트랙에 진입했다는 점에서 의미가 크다.
사진 제공 = SK바이오팜
사진 제공 = SK바이오팜
국내 RPT 기업들과 비교하면 SK바이오팜의 방향성은 더욱 뚜렷해진다. 퓨쳐켐은 전립선암 중심 파이프라인에서 속도를 내고 있고, 셀비온은 생산·공급망 역량, 듀켐바이오는 CDMO 인프라에서 강점을 보인다. 반면 이들 기업이 밸류체인의 특정 구간에 집중돼 있다면, SK바이오팜은 후보물질, 글로벌 임상, 공급망, 상업화까지 전 과정을 하나의 사업으로 연결하려 한다.
이 전략의 기반에는 세노바메이트 경험이 있다. SK바이오팜은 미국 법인 SK라이프사이언스를 통해 직접 판매를 수행하며 병원·보험 네트워크를 구축한 경험을 갖고 있다. 이를 통해 창출한 현금과 상업화 역량이 현재 RPT라는 고난도 영역으로 이어지고 있다.
물론 아직 갈 길은 멀다. RPT는 초기 시장이고, 임상과 상업화까지 넘어야 할 산이 많다. 단기간에 세노바메이트 같은 성과를 다시 기대하긴 어렵다.
다만 SK바이오팜의 RPT 도전은 기술수출에 머물렀던 국내 바이오가 공급망과 상업화까지 포함하는 '산업형 모델'로 나아갈 수 있는지를 가늠하는 시험대에 가깝다는 점에서 결과와 별개로 주목받는다.
 사진 제공 = SK바이오팜
사진 제공 = SK바이오팜